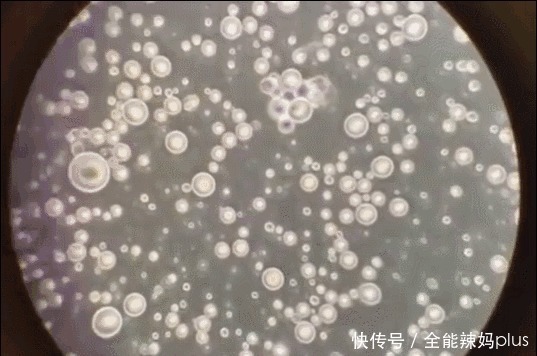
母乳|母乳是“活”的?在1000倍显微镜下长这样,纯净到令人不敢相信

母乳|母乳是“活”的?在1000倍显微镜下长这样,纯净到令人不敢相信
文|全文共1764字,阅读时间约4分钟
生了孩子之后,大部分的宝妈最害怕的事情应该就是母乳不足了。
有不少宝妈如果产后奶水不足,就会比较担心宝宝不够吃,于是自己都会去吃一些催乳的食物,奶水严重不足的,还会通过按摩来催乳。

文章插图
而不管这些方法到底可不可行,宝妈们一心想的就是让自己的奶水多一点再多一点,自己多疼多难都无所谓了。
妈妈们之所以对于母乳这么的看重,其原因也很简单,就是因为母乳对于孩子的身体帮助更为明显,而且研究人员已经通过了多项研究,证明了它的营养价值。

文章插图
母乳在显微镜下长“这样”此前就曾经有过专业的研究人员,特意做过实验来观察母乳的具体情况。该研究人员将新鲜的母乳放到显微镜下观察,当显微镜被放大了1000倍之后,母乳真的是纯净到让人无法相信。
【 母乳|母乳是“活”的?在1000倍显微镜下长这样,纯净到令人不敢相信】
文章插图
因为母乳中竟然看不到任何的杂质,有的只是脂肪球和免疫细胞,这些营养物都像“活了”一样,对孩子生长发育帮助非常大。

文章插图
看到了相关实验之后,不少网友也是纷纷表态,觉得母亲真的是非常的伟大,而母乳更是世界上最为纯净的东西。之所以很多宝妈都非常关心自己的奶水到底够不够,其实也是因为希望孩子能够喝到更健康的母乳,身体发育的更强壮。
不过也有的宝妈并不觉得母乳和奶粉有什么区别,认为喝奶粉只要喝饱了也能长大个儿。虽然奶粉可以补充孩子身体所需的营养,但是母乳当中所独有的营养成分,奶粉不一定有。

文章插图
闺蜜家孩子从小就是喝母乳长大的,而我弟媳的孩子则从小就是喝配方奶粉长大的,弟媳从小接受的是西方的观念,她总觉得母乳和配方奶粉没有区别,为了保持好身材,从孩子出生起不久,她就一直是在给孩子喝配方奶粉,没让孩子喝过母乳。
但现在弟媳就很后悔,总和我念叨说她家孩子三天两头的生病要上医院,但闺蜜家孩子体质就比较好,从上了幼儿园之后基本上就没去过医院了。而且闺蜜经常跟我提起他家孩子参加什么平衡车比赛获奖,看来孩子的身体真的是健壮。

文章插图
从两个孩子的区别中,我们也可以看出母乳和配方奶粉的区别还是很明显的。而如果说自己有母乳的话,还是尽量给孩子喝母乳的好。那么母乳和配方奶粉究竟有哪些区别呢?以下这几大区别是我们不可忽视的。

文章插图
母乳这三大方面,“无可比拟”一、母乳和配方奶粉成分区别明显
母乳和配方奶粉在成分上就有本质上的区别。母乳是属于纯天然的营养品,吸收速度相对较快,孩子喝了之后,一般都能够很快的将营养消化和吸收。
但是奶粉就不一样了,虽然说现在有很多配方奶粉,他们会刻意的去接近母乳,但还是后天人工合成的,这和天然的母乳还是存在一定差距的。
- 行程卡|行程卡带“*”会被隔离吗 行程卡带星号要核酸检测吗
- 开端|《开端》结局是be了吗 《开端》大结局是什么
- 到了孕晚期,这几个“卸货”的信号,孕妈们要注意
- 备孕干货来了,正在备孕的你别慌,学会找准排卵期“好孕”来得快
- 无影手奶爸|“无影手奶爸”抱着娃“偷吃”雪糕火了,娃就说是不是玩不起
- 父母|孩子如果出现下面几点,证明是被父母宠溺坏了,要赶紧纠正
- 目标感|孩子懒惰没有目标?比定目标更重要的,是培养孩子的“目标感”
- 你的动机是好的,行为却并不智慧
- 天使科普:这些表现是孩子智力低下的早期信号,家长可以注意了!
- 萱萱|伺候儿媳坐月子,三方面要多忍让,是诱发“婆媳矛盾”的关键点
